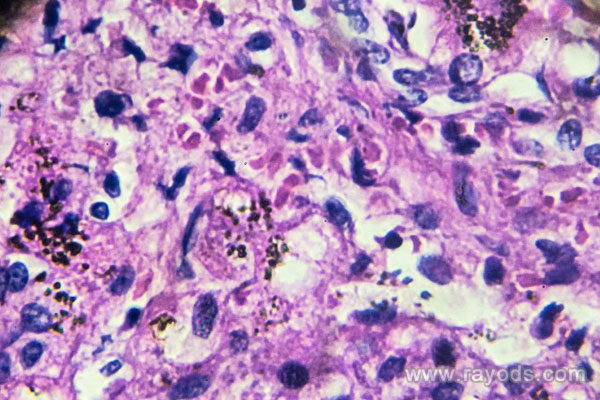

阴道炎的病因是什么?阴道炎的症状和危害有哪些?
- 试管婴儿百科
- 2026-03-25 09:25
阴道炎是一种常见的女性疾病,它不仅会带来各类不适,还可能影响到性生活和怀孕,因此一定要多加重视。那么,阴道炎的病因是什么?阴道炎的症状和危害有哪些?阴道炎吃什么好?阴道炎又该如何预防和治疗?
阴道炎的病因
原因
其为做常见的妇科疾病,常见症状为外阴瘙痒、阴道分泌物增多。若未给予重视及时治疗,甚至可致使不孕、癌变等后果。此症的主要病因主要有以下几点:
1.阴道内环境破坏
正常情况下,女性阴道内会有很多微生物群体,形成一种相互制衡、协调发展的关系,维持了阴道的生态平衡。如果女性体内雌性激素减少,或者因为性生活过多等原因导致阴道酸碱值增加,会阻碍乳杆菌的生长。此外过长期服用抗生素或者身体抵抗能力较差,都会使乳杆菌生长受到阻碍,使其他致病的细菌处于优势地位,从而导致炎症。
2.病原体入侵
当女性身体内在或者外在环境出现改变后,阴道自身的防御能力受到冲击,导致易被病菌感染,进而引发阴道炎。如果曾患盆腔炎、不洁性交史或有阴道损伤,那么患阴道炎的几率更大。
3.幼女及绝经后女性雌激素低下
年幼的女性阴道发育尚不成熟,不成遮挡住尿道口和前庭,易被细菌感染。而且由于年幼的女性体内雌激素较少、阴道酸碱值较高等原因,患上阴道炎的可能性很大。而已经绝经的女性也因为体内雌激素比较少、阴道免疫能力不足等原因容易被细菌侵入,易引发炎症。
反复发作的原因
1.用药不规范,治疗不彻底
一般需要坚持用药两个星期,并且在下次生理期来的时候开始第二个疗程,一般需要坚持三个疗程。部分患者使用三到五回后发现症状有所缓解就不再用药。但是这样会导致炎症容易复发,而且病菌逐渐会对药物产生抵抗作用,不利于彻底治愈。
2.伴侣传染
如果患者有性伴侣,那么很有可能会让对方也患上炎症。若因为病症轻微忽视治疗,那么易致使对方反复感染。女性患有阴道炎后需要停止性生活,直到疾病治愈。如果女性反复感染此症,那么伴侣也需要去医院治疗。
3.使用卫生护垫
如果女性有经常使用卫生护垫的习惯,阴道温度不仅会偏高,而且湿度会增加,这就为病菌繁衍创造有利条件。气温较高的夏天和生理期是阴道炎最易复发的时段,因此要注意清洁。生理期一定要注意经常更换卫生棉,平常生活尽量不用卫生护垫,以保证私密处干燥、通风。
4.患有糖尿病
如果患者本身患有糖尿病,那么其自身免疫能力较差,且由于阴道上皮组织的糖元含量超标,可致阴道酸碱值偏高,因此患上阴道炎。如果病情反复,且病因不明,那么需要检查血糖,看是否患有糖尿病。
阴道炎的症状和危害
症状
1.滴虫性阴道炎
症状:患者会发现白带分泌增加,颜色为乳白色或发黄,形如泡沫,有时会带脓,还会散发出异味。如果情况严重,会带血,出现尿痛、尿频、血尿。
2.霉菌性阴道炎
症状:患者会感觉阴道发痒疼痛,白带增多,形如豆腐渣。有时排尿会很频繁,并且感觉到疼痛。如果去医院做检查,结果会显示患病女性的小***和阴道黏膜都会分泌出白色物质,将分泌物拭去后发现黏膜已经发红肿胀。如果患有急性阴道炎,黏膜甚至会溃烂。
3.细菌性阴道炎
症状:白带分泌增多,形如泡沫且较稀,颜色呈现灰白。此外患者的阴道粘膜会出血,甚至可以看到出血的地方;患者不仅会感觉到疼痛而且会感觉外阴发痒,且可以闻到阴道发出的异味。
4.非特异性阴道炎
症状:阴道有下坠感和烧灼感,盆腔不舒适,身体无力;阴道分泌物变多,看上去像脓,且可以闻到怪味。由于分泌物刺激尿道口,所以可导致尿频、尿急等。
5.老年性阴道炎
症状:患者白带分泌量变多,颜色发黄,形如水或者脓,且可以闻到异味。倘若病症比较严重,那么患者可能会感觉到阴道灼热、疼痛;若是炎症蔓延到前庭和尿道口的黏膜处,那么患者小便时会感觉到疼痛,小便比较频繁。
CJM育儿资讯网-试管常识全方位解读,助您开启好孕之旅
危害
1.一般女性患病的危害
此症会导致阴道分泌物质增多,对精子穿透力造成影响,从而影响受孕能力。如病情不是很严重,那么一般不会影响到怀孕。但是如果情况比较严重,那么应该等到治愈后再准备怀孕。
2.怀孕女性患病的危害
如果治疗不够及时,若是发生感染会对腹中孩子造成影响,不仅会长红疹,脐带上还会长出形如针尖的黄色斑点。如果是顺产,那么大概有百分之六十六的孩子会得鹅口疮和臀红,所以应该等疾病痊愈后再怀孕。
阴道炎吃什么好
吃什么好
1.多吃富含维生素B的食物。比如鸡肉、小麦、高粱、豆腐等,多吃瓜果蔬菜。
2.应该多吃一些清淡软糯的食物,比如粳米、红枣、蛋类、粳米等补气益肾食物。
3.忌吃辛辣食物。以免造成身体燥热,阴道痒痛,加重病情。
4.忌吃海鲜发物。带鱼、虾等食物会让瘙痒加重,使炎症不容易缓解。
5.忌吃甜腻食物。比如奶油之类的食物会增加身体湿气,导致白带分泌变多,影响治疗。
食疗
1.淮山鱼鳔瘦肉汤
食材:淮山药30g,猪瘦肉250g,鱼鳔15g,调味料。
步骤
(1)将淮山药和肉洗干净后切成小块,鱼鳔泡在水利,洗干净后切成细丝。
(2)然后把材料放入锅中,加入适量水,用大火煮开后改成小火煮两个小时,然后加入调味料即可。
功效:滋阴补肾,抑止白带过度分泌。
2.马鞭草猪肚汤
食材:马鞭草30g,猪肚100g,调味料。
步骤:
(1)将食材洗干净后,马鞭草切成小段,猪肚切成片状。
(2)然后在煮开的锅中加入食材煮开。去渣喝汤,一天一次。
功效:解毒杀虫,去除燥热。但是孕妇和脾胃不佳的人群要慎用。
3.淡菜芡实墨鱼汤
食材:淡菜100g,墨鱼(干品)50g,芡实20g,猪瘦肉100g,调味料。
步骤:
(1)将淡菜和墨鱼泡在水中,洗干净后切成段。
(2)将处理好的食材全部倒入砂锅中,加入适量水,大火煮开后用小火熬两个小时,然后加入调味料。
功效:滋阴清热,促使白带收敛。
阴道炎如何预防和治疗
如何预防阴道炎
1.私处涂抹要谨慎:有的女性有在阴道处喷香水、涂抹保养品的习惯,若是使用不当会对外阴和阴道粘膜造成一定的刺激,可能引起过敏。
2.注意清洁私处:勤换内裤,上完厕所后用纸擦拭时应该由前至后,避免让阴道感染细菌,从而诱发阴道炎。
3.少穿紧身裤:尽量少穿类似牛仔裤的紧身的裤子,天气炎热时可以穿裙子或者比较宽松的衣物,因为阴道较为潮湿,穿太紧的裤子的话通风不便,女性容易得阴道炎。不要穿紧身尼龙内裤,应该穿棉内裤。
4.使用无香味添加剂的卫生用品:为了减少刺激,最好用未添加香味剂的卫生用品。如果需要清洗阴道,可以用温水清洗,不要随便用消毒药水,以免导致炎症。
如何治疗阴道炎
1.细菌性阴道病
治疗原则:选择抗厌氧菌的药物,比如甲硝锉、克林霉素等。
(1)口服药物:最好是甲硝唑。
(2)局部药物治疗。
(3)性伴侣不用进行常规治疗。
2.念珠菌性阴道炎
(1)消除诱因:如果患有糖尿病,应该积极治疗,及时停用广谱抗生素、雌激素和皮质醇。经常更换内裤,毛巾、内裤等要用开水洗。
(2)局部用药:可以使用咪康唑栓剂、克霉唑栓剂等药物。
(3)全身用药(反复发作或阴道不能用药的患者):可以使用氟康唑、伊曲康唑等药物。
(4)性伴侣不必接受常规治疗。
(5)如果患有妊娠合并假丝酵母菌引发的阴道炎,一般采取局部治疗,但是千万不可以服用唑类药物。
3.滴虫性阴道炎
(1)局部用药:甲硝唑阴道泡腾片或者浓度为0.75%的甲硝唑凝胶疗效不错,浓度为1%的乳酸或者浓度为0.5%的醋酸可以用来洗阴道,也可以起到治疗的效果。
(2)全身用药:第一次可以选择服用甲硝唑,但是出现不适后需要立即停用。服用甲硝唑期间及停药一天内,替硝唑用药期间及停药三天内不可以喝酒,哺乳期用药不要给孩子喂奶。
(3)性伴侣需要同时进行治疗,治愈前不要有性生活。
4.老年性阴道炎
治疗原则:提升体内雌性激素水平,提高身体免疫力,避免受到细菌感染。
5.幼女性阴道炎
治疗原则:外阴一定要保证干净,选用药物时要对症下药,必要时可以选择服用抗生素。
霉菌性阴道炎
1.定义
霉菌性阴道炎(VVC)是外阴阴道假丝酵母菌病,是由假丝酵母菌引发的常见阴道炎。病原体多为白假丝酵母,占到总数八九成,其余情况是光滑假丝酵母等病菌。
2.症状
患者会感觉外阴发痒等,有些患者会出现阴道分泌物增多的情况,分泌物中含有菌丝体等,状如凝乳或豆腐渣,比较浓稠,颜色发白。当患者排尿的时候,尿液刺激到外阴和前庭会让患者感觉到疼痛。通过检查会发现患者外阴发红、有抓痕等。如果病情比较严重,患者的皮肤还会龟裂。此外会发现患者的小***粘膜红肿不堪,且会分泌白色物质。如果正处于急性期,阴道会有糜烂、溃疡情况。
3.治疗
(1)消除诱因
若患者还患有糖尿病,则需要主动治疗。需要注意的是,不要使用雌激素、广谱抗生素等药物。需要讲究个人卫生,勤换内裤,贴身衣物和毛巾等要用热水烫洗。
(2)单纯性VVC
局部和全身用药都可以,主要是局部短时间服用抗真菌的药物。疗效相似,治愈率在八到九成,唑类药物比制霉菌素疗效好。
a.局部用药
可以选择一下药物放入阴道:咪康唑栓剂,每晚一粒两百毫克需要用七天,每晚一粒四百毫克需要用三天,一粒一千二百毫克只要用一次。克霉唑栓剂,每晚一粒一百五十毫克需要用七天,每日早前各用一粒一百五十毫克的药物,连用三天,一粒五百毫克的药物只用一次。制霉菌素栓剂,每晚一粒十万U,连续使用十到十四天。
b.全身用药
若耐受性较差,不愿局部用药的女性可以选择口服药物。一般使用氟康唑一百五十毫克。
(3)复杂性VVC
a.严重VVC
口服药物和局部用药都需要延长时间。如果是局部用药,延长七到十四天;如果是口服氟康唑一百五十毫克,三天后再吃一次。如果病情较重,局部还需要使用浓度低的糖皮质激素软膏或是唑类霜剂。
b.复发性VVC
若1年之中出现炎症症状,并且经证实的VVC发作四回就表示是复发性,几率是百分之五。多数患者发病原因不明确,抗真菌治疗分为初始治疗和巩固治疗。初次治疗是局部治疗,延长一到两个星期;如果口服氟康唑一百五十毫克,那么第四天、第七天需要加服一次。巩固治疗方案:可以选择服用氟康唑,每七天服用一次,一次服用一百五十毫克即可,需要持续半年时间;如果已经确定炎症复发的规律,那么也可以根据推断在疾病复发前先局部治疗。
治疗前需要进行真菌培养确诊。治疗期内要定期复查,这是为了检查治疗效果和药物是否有副作用,一旦发现有副作用要立即停药。
细菌性阴道炎
1.定义
简称BV。由于引导菌群失衡而造成的炎症。正常阴道应该是乳杆菌较多,如果患上此症,那么乳杆菌就会变少,导致其他微生物变多,主要有厌氧菌等,厌氧菌可以增加一百到一千倍。
2.症状
百分之六十到九十患者有临床症状。主要的症状有阴道分泌物增加,且有鱼腥臭味,这是因为病菌会产生胺类物质;患者会感觉外阴瘙痒且有灼热感,一般这些症状在性交后会加重。但是通过检查会发现患者阴道膜没有出血情况,且粘膜会分泌灰白色的物质,均匀但是比较薄,比较容易拭去。
3.治疗
治疗原则:选用抗厌氧菌药物,比如甲硝唑等。甲硝唑可以阻碍厌氧菌繁衍,但乳杆菌不受其影响,但是治疗支原体的效果不佳。
(1)口服药物
首选甲硝唑四百毫克,每天吃两次,口服,总共是七天;或替硝唑两克,口服,每天一次,连续吃三天;或替硝唑一克,口服,每天一次,连续吃五天;或克林霉素三百毫克,每天两次,连续吃七次。甲硝唑两克,顿服的效果不好,所以不推荐。
(2)局部药物治疗
含甲硝唑栓剂两百毫克,每晚一次,连续吃七天;或浓度为百分之二的克林霉素软膏涂抹阴部,每次五克,每晚一次,连续用七天。口服和局部用药效果相似,治愈率在八成左右。
(3)随访
治疗后没有症状就不需要常规随访。此种炎症容易复发,若持续或反复出现症状,就需要在刺激接受治疗。但是选用的药物不同,可以选用阴道乳杆菌制剂。
滴虫性阴道炎
1.定义
由阴道毛滴虫造成,是一种常见的阴道炎。滴虫嗜血,且不怕碱环境,生理期前后阴道酸碱度发生改变,导致滴虫繁衍,诱发炎症。
2.症状
阴道分泌大量物质,出现外阴疼痛,偶尔有发痒、性交痛等情况。分泌物稀薄,黄绿色,泡沫状,而且有臭味。因为分泌物中有白细胞,所以看上去像脓;由于滴虫可以将碳水化合物分解,所以分泌出来的物质会有臭味,且形状就像泡沫一样。患者会感觉到外阴处和阴道口发痒,如果尿道口也被感染,那么会有尿频、尿痛甚至血尿情况。
阴道毛滴虫可以吞噬精子,因此可能会导致女性不孕。女性去医院检查后发现阴道粘膜红肿,情况严重时阴道会有斑点,甚至蔓延到宫颈处,宫颈像草莓样。除此以外,后穹窿会分泌出大量形状像泡沫的白带,为灰白色或黄白色液体,也可能是黄绿色像脓一样的物质。但是带虫的女性阴道没有什么症状。
3.治疗
(1)全身用药
初次治疗可选择甲硝唑两克,单次口服;或替硝唑两克,单次口服;或甲硝唑四百毫克,每天两次,连续吃七天;或替硝唑五百毫克,每天吃两次,连续吃七天。女性患者口服治愈率是百分之八十二到八十九,如果性伴侣同时治疗,可以达到百分之九十五。
服药期间出现肠胃反应,例如呕吐、食欲不振,以及头疼、皮疹等,需要立即停药。治疗期间以及停药一天内,不可以喝酒,以免药物和乙醇反应引起皮肤发红、呕吐等。甲硝唑可以通过乳汁排泄,如果哺乳期用药,那么用药期间和用药后一天内不可以喂奶。服用替硝唑的人,吃药三天内不可以喂奶。
(2)性伴侣的治疗
此种炎症主要的传染途径是性生活,因此男方也需要进行治疗,治疗期不要同房。
(3)随访
此种阴道炎不必进行随访,一旦出现症状就要去治疗。部分患者会再次感染,一般在生理期后,所以需要随访直到症状消失。若是症状持续存在,那么治疗后七天要复诊。如果初次治疗失败,需要加大药剂量和疗程。可以重复使用甲硝唑四百毫克,每天两到三次,连续服用七天。如果治疗失败,可以服用甲硝唑两克,每天一次,连续服用三到五天。
(4)治疗注意事项
如果有复发症状,多数是重复感染,为了避免此情况,需要高温消毒杀菌患者食物内裤和洗涤的毛巾,煮沸五到十分钟可以消灭病原体,并且对性伴侣进行治疗。
非特异性外阴炎
1.定义
这是一种由物理、化学原因或者链球菌、葡萄球菌之类的病菌造成的阴道炎,而不是因为感染滴虫等,并且此种炎症还会受到各种厌氧菌、支原体的影响。
2.症状
患者会感觉阴道粘膜发痒和疼痛,此外还有灼热感,当患者有性交、小便之类的活动时症状会加重。去医院检查时会发现患者外阴红肿、糜烂等。情况比较严重时阴道会溃疡。如果患有的是慢性炎症,那么患者的皮肤会变粗糙、变厚等。
3.治疗
治疗原则:为了保持局部干净、干燥,可以使用抗生素,要致力于清除病菌。
局部治疗
可以使用浓度为0.1%聚维酮碘液或1:5000高锰酸钾洗澡,每天两次,每次是十五到三十分钟。洗完后涂抹抗生素软膏或者紫草油。还可用中草药加水煎煮熏洗私处,每日一两回。若处于此症急性期,可以考虑其他治疗法,比如微波护红外线局部物理治疗。
病因治疗
患者治疗疾病的态度一定要积极。如果本身患有糖尿病或尿瘘等病症,那么也要注意治疗。

发表评论